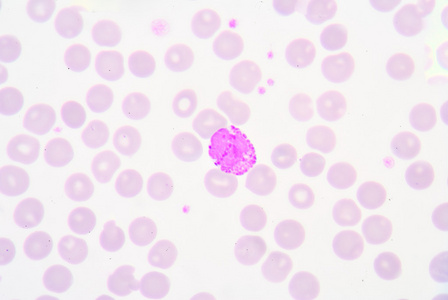
嗜碱性粒细胞图片-嗜碱性粒细胞素材-嗜碱性粒细胞插画-摄图新视界

嗜碱性细胞

血液科实验室学习 - 美篇
图片尺寸1198x718
"国药杯"在线形态学读片比赛图片集 - 美篇
图片尺寸2456x1842
梅小lady的美篇 - 美篇
图片尺寸1164x1014
秀山医学检验质量控制中心第二十六期形态学培训答案解析 - 美篇
图片尺寸904x976
看图识细胞之"卫生部2017年第1次血细胞形态学质控"-健康频道-手机搜
图片尺寸640x522
01炎症 病理学_word文档在线阅读与下载_无忧文档
图片尺寸1080x810
嗜碱粒细胞的介绍_百度知道
图片尺寸280x220
新生儿外周血形态特点 - 美篇
图片尺寸1200x1600
生命核动力:食疗养生~细胞营养的基础就是细胞!每个细胞都有自己的生
图片尺寸720x558
图176 嗜碱性粒细胞白血病血象-血液学细胞学-医学
图片尺寸1140x913
血常规检查中,如果这3个指标升高,要提高警惕,别大意
图片尺寸533x400
cnsl脑脊液中的嗜碱性粒细胞_医学界-助力医生临床决策和职业成长
图片尺寸534x534
镜下白细胞辨别 - 知乎
图片尺寸1536x2048
一医青年专家说科普③丨朱丽青:解密血常规报告_红细胞
图片尺寸760x642
嗜碱细胞
图片尺寸1200x803
人血涂片ppt_word文档在线阅读与下载_无忧文档
图片尺寸1080x810
涂片显示嗜碱性粒细胞
图片尺寸1200x800
嗜碱性粒细胞比率偏高说明什么(嗜碱性粒细胞比率偏高说明什么得了甲
图片尺寸641x561
嗜碱性粒细胞图片-嗜碱性粒细胞素材-嗜碱性粒细胞插画-摄图新视界
图片尺寸448x300
临床基本功│粒细胞正常与异常形态 --生命经纬
图片尺寸546x425